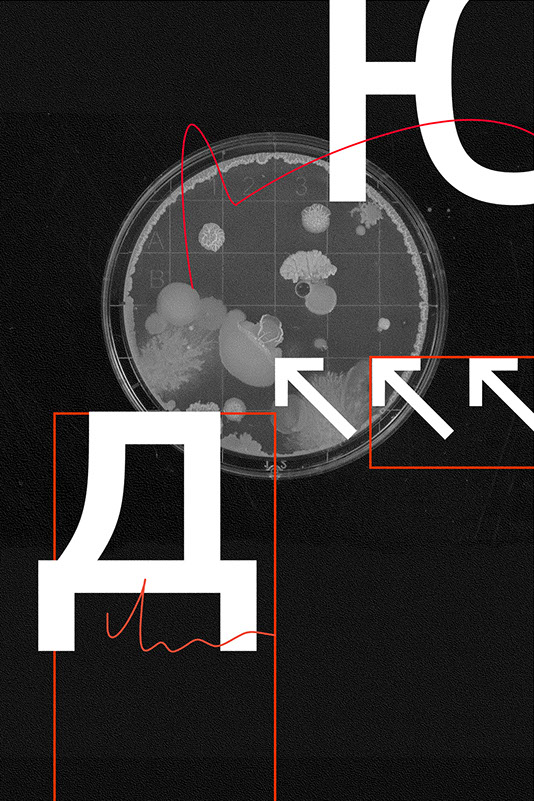

Composition typographique
Composition typographique
Illustration déclinée en de nombreuses compositions
Illustration déclinée en de nombreuses compositions
Illustration déclinée en de nombreuses compositions
Exercice de style
Spécimen de typographie
Affiche des journées portes ouvertes de l'ÉSAD Orléans
Affiche réalisée dans le cadre d'un événement pour les 70 ans d'Emmaüs Ormes
Affiche pour un projet fictif d'un festival hors connexion.
Exercice de composition.
Exercice de composition.
Exercice de composition.
10 - 13
<
>